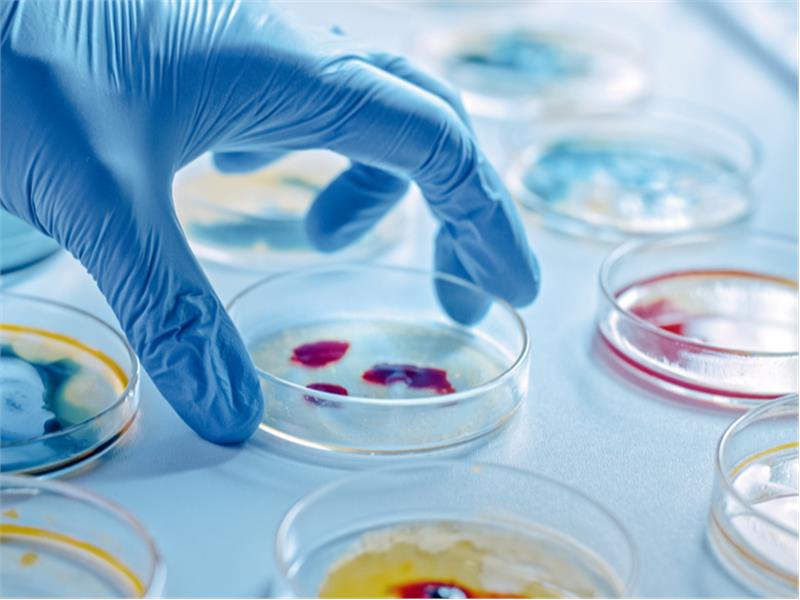

- Anasayfa
- Firma
- ACIBADEM SAĞLIK YATIRIMLARI HOLDİNG ANONİM ŞİRKETİ
- Haberler
- ENFEKSİYONUN EN AĞIR HALİ: SEPSİS!
-
Geri dön
-
3.109 Görüntülenme
-
1141 Haber
-
609 İşletme görüntülenme

(13 EYLÜL DÜNYA SEPSİS GÜNÜ)
Dünya yaşlanıyor, Sepsis oranı artıyor!
Her yıl 12 milyon kişi Sepsis nedeniyle hayatını kaybediyor!
Az biliniyor ama ölüm nedenleri arasında ilk sıralarda…
ENFEKSİYONUN EN AĞIR HALİ: SEPSİS!
Sepsis için kısa bir tanımlama gerekirse “vücuttaki en ağır enfeksiyon hali” denilebilir. Sepsiste vücut, ağır enfeksiyonlara aşırı tepki verir. Bu, öyle ileri düzeyde bir tepki olur ki, organ yetmezliğinden hayat kaybına kadar önemli sonuçlara yol açar. Halk arasında “kan zehirlenmesi” olarak da bilinen sepsisin nedeni; virüs ya da bakteriler. Peki, hayatımızın çeşitli dönemlerinde farklı nedenlerle enfeksiyon atlattığımız halde, enfeksiyon nasıl en ağır hale gelerek sepsise dönüşüyor? Hayatı nasıl tehdit edebilir hale geliyor? Önlem almak mümkün mü? Bu soruları Acıbadem Ataşehir Hastanesi Yoğun Bakım Sorumlusu Prof. Dr. İsmail Cinel’e sorduk ve sepsis hakkında bilinmesi gerekenleri öğrendik.
Dünyada her 5 kişiden birinin ölüm nedeni, sepsis! Hal böyle olunca, sepsis riskini bilmek, düşünmek ve önlem almak gerekiyor. Üstelik yalnızca tıp dünyasının değil, bireylerin de aktif olarak alabileceği önlemler var. Covid-19 pandemisi, dünya çapında enfeksiyonların yol açabileceği büyük riskleri hepimize hatırlattı. 2 yıl boyunca milyonlarca cana mal olan ve hayatımızı alt üst eden pandemi sürecinde pek çok hasta yoğun bakım tedavisi gördü. Ancak Covid-19 nedeniyle yoğun bakımda tedavi gören ve hayatını kaybeden her yüz hastadan 95’inin ölüm nedeni, Covid ilişkili sepsis oldu. Prof. Dr. İsmail Cinel, “Sepsiste vücut, enfeksiyonlara karşı anormal ve düzensiz yanıt veriyor; organların işlevi bozuluyor ve yetersiz kalıyor. Dolayısıyla sepsis, yaşamı tehdit eden klinik bir tablo haline geliyor. Sepsis, ancak yoğun bakım servislerinde tedavi edilecek bir hastalık ve yine yoğun bakımların en ölümcül hastalığı olarak kabul ediliyor” diyor.
Bağışıklık düzeyini yükseltin
Sepsis, dünyada her yıl 12 milyon insanın ölümüne yol açıyor. Üstelik bebeklikten yaşlılığa kadar her dönemde kişinin karşılaşabileceği bir risk. Tıp dünyasında sepsis riskini düşürecek yeni tedavi yöntemleri kadar önleyici yöntemlerin de araştırıldığını belirten Prof. Dr. İsmail Cinel önemli uyarılarda bulunuyor. “Kişilerin de bu riskten uzak durmak için yapması gerekenler var. Öncelikle kişisel temizliğe dikkat etmek gerekiyor. Elleri yıkamak çok ama çok önemli. Araştırmalar enfeksiyon etkenlerinin en sık eller yoluyla vücudumuza girdiğini gösteriyor. Elleri yıkamak kadar damlacık yoluyla bulaşın artığı salgın dönemlerinde maske kullanımı da yaşamsal öneme sahip. Onun dışında bağışıklığını güçlü tutacak; sağlıklı beslenme, düzenli uyku, egzersizi hayatının olmazsa olmazları haline getirmesi gerekiyor. Zira enfeksiyonlar bağışıklığın düşük olduğu zamanlarda daha ağır seyrediyor” diyor. Ancak her zaman bağışıklığı bu yollarla yükseltmek mümkün değil. Bazı genetik ya da kronik hastalıklarda ve bazı durumlarda bağışıklık düşük seyrediyor ki bu da enfeksiyonlara davetiye çıkması, bazen de sespis gelişmesi anlamına geliyor.
Kimler risk altında?
Hastanede yatan hastaların ölüm nedenleri arasında ilk sırada yer alan sepsisin hastaneye tekrar yatışlarda da yine listenin başında yer aldığını belirten Prof. Dr. Cinel, risk altındaki gruplar hakkında şu bilgileri veriyor:
“1 yaş altı bebekler veya 75 yaş üzeri kişiler, kronik hastalar, hamileler, kanser gibi bağışıklık sistemini baskılayan hastalar, organ nakli ameliyatı geçirenler ve uzun süre yoğun bakımda ya da hastanede yatan kişiler daha fazla risk altında oldukları için bu gruplarda enfeksiyon gelişmesi açısından belirli zamanlarda risk faktörlerinin değerlendirilmesi, immunizasyon ya da bağışıklamanın gözden geçirilmesi ve tamamlanması sepsis riskinin gelişmesini önlemek açısından çok önemli!”
Dünyada giderek yaşlı nüfusun artmasının sepsis riskini artıracağını belirten Prof. Dr. İsmail Cinel, bu durumun genellikle yaşlılarda bağışıklığın gençlere göre daha düşük olmasından kaynaklandığına dikkat çekerken “Sepsis gelişen hastaların 2/3 kadarının yaşlılar olduğu tahmin ediliyor. Sepsis tanısı konduktan sonra 28 gün içinde hayatını kaybeden 75 yaş üstü hastalarda, sepsise yanıt olarak görülen klinik ve laboratuvar değişikliklerin orta yaşlılara göre daha hafif veya yüzeysel olduğu görülüyor. Bu hastaların üçte birinde kan ve enfeksiyon yerinden alınan kültürler de negatif sonuçlanıyor yani yaşlılarda sepsis tanısı daha zor konuyor” diyor.
8 önemli belirti var!
Acıbadem Ataşehir Hastanesi Yoğun Bakım Sorumlusu Prof. Dr. İsmail Cinel sepsisin önemli 8 belirtisini şöyle sıraladı:
• Titreme, ateş veya vücut ısısında düşüklük,
• Şiddetli halsizlik/kas ağrıları,
• “Ölecek gibi” hissetme,
• Bilinç değişikliği/sersemlik,
• Sık nefes alıp verme/nefes darlığı,
• Öksürük,
• Kalp çarpıntısı/nemli ve soğuk cilt,
• Gün boyu idrar yapamama
Bunlardan bir ya da bir kaçının görüldüğü durumlarda acilen en yakın sağlık kuruluşuna gitmek gerekiyor.
Erken tanı hayat kurtarıyor
Çok ciddi hayati riskler taşıyan sepsiste, pek çok hastalıkta olduğu gibi erken tanı çok önemli. Bunun için toplumda öncelikle sepsis farkındalığının artırılması gerektiğini vurgulayan Prof. Dr. İsmail Cinel şunları söylüyor: “Toplumsal farkındalık, önlenebilir ölüm nedenlerinin başında gelen sepsisin görülme sıklığını da düşürecektir. Farkındalık şu şekilde olmalı: Öncelikle kişisel temizlik konusundaki bilinç yükselmeli. Sık sık ellerin yıkanması, yiyecek ve içeceklerin hijyenine dikkat edilmesi gibi. Enfeksiyonlara karşı aşı olmak da olası hastalık risklerini bertaraf eder. Ayrıca özellikle bağışıklığı düşük kişilerin enfeksiyon belirtilerini ciddiye alması, hastaneye başvurmayı ötelememesi erken tanı olanağını da artırarak, tedavi başarısının yükselmesini sağlar.”
Kurumlara düşen roller de var!
Prof. Dr. İsmail Cinel, kişiler kadar, tüm dünyadaki kurum ve kuruluşlara da bu konuda rol düştüğünü belirterek “Temiz su kaynaklarının sağlanması, kamusal temizliğe dikkat edilmesi gibi yönetimlerin yapacağı görevlerin yanı sıra hastanelerde doğum yapılan ortamların hijyeni, özellikle yoğun bakımlar ve ameliyathaneler başta olmak üzere enfeksiyon önleyici uygulamalara sıkı şekilde uyulması, doğru tedavilerle hastanede yatış sürelerinin kısaltılması, hastanelerdeki sağlık çalışanlarının, değişim hızının az olması, hastanelerde havalandırma sistemlerinin son teknoloji ile donatılmış olması gibi faktörler de sepsis gelişme oranını düşürecek önlemlerdendir” diyor.
Habere Ait Görseller
- 13 Eylül 2023 Çarşamba 13 Eylül 2023 Çarşamba
İşletmenin Diğer Haberleri
Mesaj GönderKAPAT
İşletmeye mesajınızı iletin.
Not: Mesajınız iletilmeden önce kalite ve politikalar gereği incelenebilir.